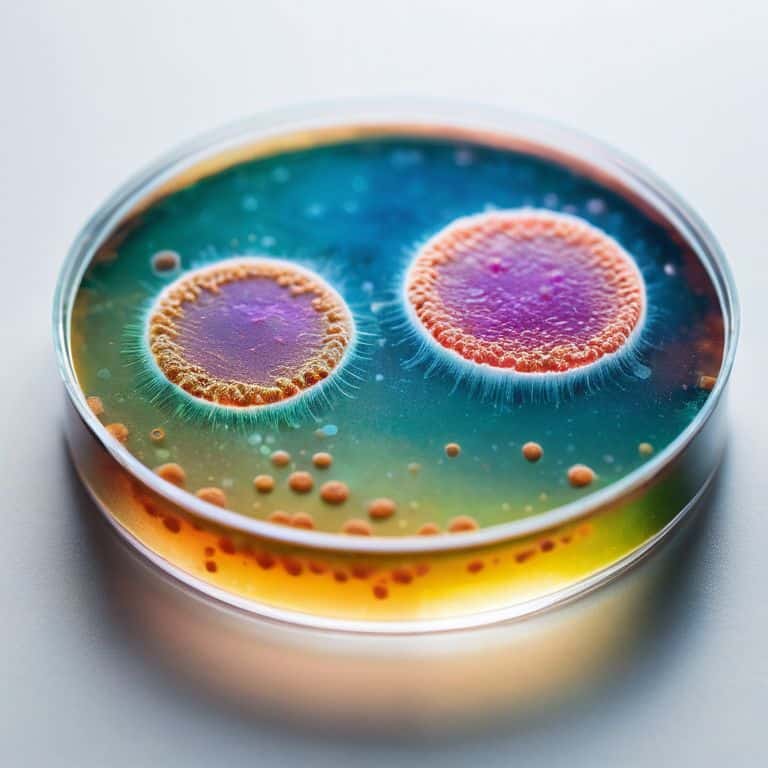
Virus vs bacteria difference explained

Timeless Sound: Retrofitting Vintage Hi-fi for Bluetooth 5.4
Most people swear that retrofitting vintage Hi‑Fi for BT 5.4 requires a specialist’s lab, a stack of schematics, and a budget…
Your Source for Industry Insights and Analysis

Most people swear that retrofitting vintage Hi‑Fi for BT 5.4 requires a specialist’s lab, a stack of schematics, and a budget…

I still remember the day I learned to whistle with fingers – it was a game-changer for me, and I’ve…

I still remember the first time I stumbled upon the concept of what is nuclear fusion energy. It was during…

I still remember the day I stumbled upon a web of interests that changed my perspective on the geopolitics of…

I still remember the first time I dug into the world of how a power grid works. As an investigative…

As I dug into the world of a guide to renewable energy sources, I couldn’t help but notice the overwhelming…

I still remember the first time I encountered a clogged sink P-trap in my own home – the frustration of…
I still remember the countless hours I spent in the investigative unit, digging into the financial forces behind public health…

I still remember the day I stumbled upon the concept of what is herd immunity while working on a story…

As I delved into the world of global health, I discovered a startling truth: the World Health Organization (WHO) is…